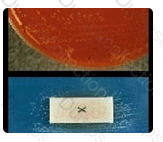

Mrs. Jones, a diabetic, is admitted to the hospital on November 25th. It appears that she has had an AMI but did not feel the severe chest pain because of diabetic neuropathy. She has not felt well since November 20th and her physician believes she possibly had an AMI on November 20th.
Assuming that the infarct was uncomplicated, which of the following cardiac biomarkers would most likely still be elevated and would assist in an AMI diagnosis?
Haemophilus influenzae is both X and V factor dependent for growth, and is the most common cause of obstructive laryngitis and epiglottitis. H. parainfluenzae is only V-factor dependent and causes only mild pharyngitis, rarely obstructive in nature. H. aphrophilus can be part of the normal upper respiratory flora in humans, does not cause pharyngitis, and is not X or V-factor dependent for growth. Although H. haemolyticus is both X and V-factor dependent, it is beta hemolytic on blood agar and is generally considered non pathogenic.
Acute obstructive epiglottitis, both in adults and children, is caused by the bacterial species shown in this split screen photograph. The colonies recovered on chocolate agar (upper frame) required both hematin and NAD, (as shown by colony growth only between the X and V strips in the lower frame). The most likely identification is:
In combined fiscal years 2005 through 2009, transfusion-related acute lung injury (TRALI) caused the higest number of reported fatalities (48%), followed by hemolytic transfusion reactions (26%) due to non-ABO (16%) and ABO (10%) incompatibilities. Complications of microbial infection, transfusion-associated circulatory overload (TACO), and anaphylactic reactions each accounted for a smaller number of reported fatalities.
This type of laboratory professional is responsible for the technical aspects of managing the operation of the laboratory and is most likely an MLS with additional education in administration:
hs-CRP is a recent marker of chronic inflammation. New measurements of CRP in lower levels (hs-CRP) are now measured to monitor risk of cardiovascular disease.
Select the statement that best describes hs-CRP?
Neutrophils, lymphocytes and macrophage/ monocytes can be found in all types of body fluid differentials. Bronchial cells can be found only in bronchial washings and BAL specimens. Mesothelial cells are found only in serous body fluids including pleural fluid, peritoneal fluid, and pericardial fluid.
Select the specific cells listed below that can be found in all types of body fluid.
Provide the equivalent measurement for 75 milligrams.
Question options:
Tan stopper tubes are used for reticulocyte counts.
Question options:
Alpha-fetoprotein is a substance typically used in the triple test during pregnancy and for screening chronic liver disease patients for hepatocellular carcinoma.
Increased concentrations of alpha-fetoprotein (AFP) in adults are MOST characteristically associated with:
RAST tests, or Radioallergosorbent tests, are used to screen for an allergy to a specific substance or substances if a person presents with allergy-like symptoms.
The assay which is most helpful in identifying specific allergens is:
Which of the following is a current title for clinical laboratory professionals with a 4 year degree?
In this case, the pH may become more alkaline, perhaps above 8.0, if the bacteria in the sample are proliferating during the extended room-temperature wait time.
A urine specimen was collected at 6:00 a.m. and remained at room temperature until it was received in the laboratory at 3:30 p.m. How may the pH of the specimen be affected by the extended time at room temperature if bacteria are present in the specimen?
Cholesterol levels do not fluctuate as triglycerides, fatty acids, lipoproteins, and chylomicrons do after an individual eats a meal. This is the reason that patients are told to fast; the laboratory needs a fasting sample to determine a lipid profile or panel which includes the latter four components.
Which of the following lipid tests is LEAST affected by the fasting status of the patient?
Provide the equivalent measurement for 4 milligrams.
What has happened in a titer, if tubes #5-7 show a stronger reaction than tubes #1-4?
TESTED 19 Apr 2026